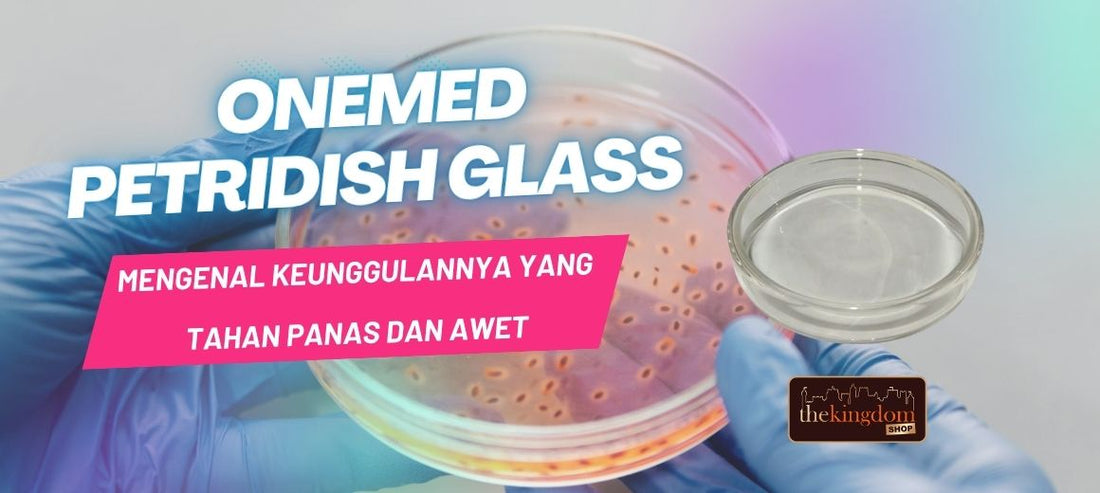
Mengenal Keunggulan Petridish Kaca Onemed yang Tahan Panas dan Awet

Get to Know the Advantages of Onemed Glass Petridishes, Which Are Heat Resistant and Durable
In the world of microbiology laboratories, the quality of the equipment used significantly impacts the results of microbiological observations and cultures. One crucial piece of equipment is the petri dish. This time, we'll discuss one of our leading local products, the Onemed Glass Petridish , known for its heat resistance and long-term durability.
What is Onemed Glass Petridish ?
Onemed Petridish Glass is a petri dish made of high-quality borosilicate glass, designed for use in research laboratories, education, and hospitals. This product is available in various sizes, such as 60x15mm , 90x18mm , 100x18mm , up to 120x25mm , providing flexibility to suit user needs.
 Main Advantages of Onemed Glass Petridish
Main Advantages of Onemed Glass Petridish
-
Extreme Heat Resistant
Onemed Glass Petridishes are made of borosilicate glass, a material that can withstand high temperatures of up to 100°C for 10-15 minutes. This means they are safe for use in autoclaves, ovens, or other heating methods without the risk of cracking or breaking. -
Long-Lasting Power
Unlike plastic Petri dishes, which can only be used once, glass Petri dishes can be reused as long as they are properly sterilized. This certainly makes them more economical for laboratories with frequent use. -
Smooth and Transparent Surface
In addition, the smooth and transparent glass surface is one of the advantages because it will really help researchers to observe and record the movement of microorganism colonies in more detail under a microscope or without any tools. -
Stable and Not Easily Scratched
Borosilicate glass is also known to be resistant to scratches and chemical reactions, making it ideal for a wide variety of culture media, including agar, nutrients, and other test materials.
Conclusion
If you're looking for a durable, sterilizable, and cost-effective petri dish, Onemed Glass Petridishes are the perfect choice. Get them here .
















